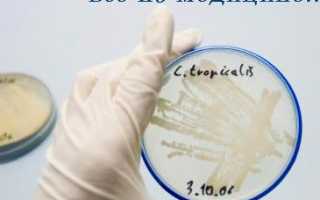
Может ли возникнуть молочница от смены полового партнера

До 80% женщин не понаслышке знают, что такое кандидоз. Иногда достаточно принять антибиотик, перенести стресс или наесться сладостей, чтобы характерные симптомы не заставили себя ждать. Но когда возникает молочница при смене партнера, есть повод задуматься: что это – просто реакция на незнакомую микрофлору или новый мужчина — переносчик инфекции?
Как проявляется молочница у женщин
Кандидозная инфекция проявляется следующими признаками:
- зудом и жжением;
- отеком;
- болью и дискомфортом при половом акте, мочеиспускании;
- творожистыми выделениями с кислым запахом.
При осмотре в зеркалах стенки вагины гиперемированы и покрыты белым налетом. Однако окончательный диагноз ставится после лабораторного исследования мазка. Он обязателен: необходимо убедиться, что это действительно молочница, а не какая-нибудь половая инфекция, тем более, если симптомы появились после секса.
Чем опасно самолечение кандидоза
Не долечившись до конца, пациентки загоняют заболевание в состояние ремиссии. Баланс микрофлоры остается нестабильным и нарушается при неблагоприятных условиях:
- колебаниях гормонального фона;
- ослаблении иммунитета;
- антибиотикотерапии;
- погрешностях в гигиене.
При длительной хронической молочнице рецидивы могут возникать от вполне безобидных для здорового организма причин: перемены климата, злоупотребления сладким, ношения синтетического белья. С каждым разом избавиться от воспаления становится сложнее. У грибков вырабатывается резистентность к препаратам, и привычные лекарства перестают действовать.
Вторая ошибка в борьбе с кандидозом: женщина лечится, а ее партнер – нет. При первых признаках заболевания рекомендуется прекратить половую жизнь и проходить терапию вместе. Пациентке – следовать рекомендациям гинеколога, мужчине — дать таблетку Флуконазола и наружный антигрибковый крем.
Однако многие считают генитальный кандидоз исключительно женской интимной проблемой, не зависящей от сексуальной активности. Мужчины достаточно редко болеют этой инфекцией, но это не значит, что они не являются носителями. Может ли быть причиной молочницы смена партнера или заражение от постоянного любовника – деликатный вопрос, который иногда способен разрушить отношения.
Может ли мужчина быть причиной молочницы
Формально кандидомикоз не относится к заболеваниям, передающимся половым путем. При сильном общем и местном иммунитете организм успешно справляется и с собственными грибками, и с привнесенными извне. Если женская микрофлора не сбалансирована или количество чуждых патогенов слишком велико, возможна передача молочницы от мужчины.
Заражение происходит при следующих условиях:
- У партнера наблюдаются явные признаки генитального кандидоза. Это зуд, жжение, покраснение, белый налет в области головки полового члена и крайне плоти, выделения при мочеиспускании, боль во время соития.
- Мужчина является бессимптомным носителем инфекции. Сам он не болеет, но передает возбудителей кандидоза при интимном общении. Такое обычно случается с партнерами женщин, страдающих от хронической молочницы. Второй вариант носительства – перенесенный и недолеченный грибковый баланит или баланопостит.
- Мужчина имел незащищенный сексуальный контакт с больной женщиной и передал заболевание другой партнерше.
- Молочница при смене партнера у женщин бывает при чувствительной слизистой влагалища. При этом новый мужчина необязательно болеет сам и даже не всегда является носителем. Для каждого человека характерны собственные состав и соотношение бактерий, что воспринимается другим организмом как чуждая флора. После периода адаптации, если сексуальная связь постоянна, рецидивы молочницы уменьшаются, а их симптоматика стирается.
- Пациентка ведет беспорядочную половую жизнь. Частая смена любовников расшатывает бактериальный баланс женских органов, приводит к хроническому вульвовагиниту грибкового происхождения. Не исключаются и другие инфекционные заболевания.
Другая проблема, если у здоровой женщины возникает дрожжевой кольпит после секса с постоянным бойфрендом. Когда дискомфорт появляется после каждого соития, есть повод задуматься не только об обследовании, но и верности в паре. Как ни печально, но хроническая рецидивирующая молочница может быть признаком измены. Но прежде чем обвинять другого человека, стоит пролечиться и исключить другие причины болезни.
Профилактика заражения молочницей
Для предупреждения грибкового заражения важно действовать в нескольких направлениях:
- укреплять общий иммунитет;
- нормализовать микрофлору;
- соблюдать интимную гигиену во всех смыслах.
Перечислим основные меры профилактики:
- избегать частой смены партнеров;
- исключить случайные контакты;
- использовать презервативы с новыми и сомнительными людьми;
- тщательно следить за личной гигиеной;
- не пользоваться агрессивными моющими средствами при туалете половых органов;
- избавиться от ароматизированных прокладок, интимных дезодорантов;
- не делать спринцевания без показаний;
- не надевать тесную одежду, сдавливающую тазовую область;
- носить нижнее белье из натуральной хлопчатобумажной ткани;
- не заниматься самолечением, особенно – не принимать антибиотики без назначения врача;
- соблюдать диету с пониженным содержанием углеводов;
- устранить кишечный дисбактериоз;
- нормализовать гормональный баланс;
- подбирать оральные контрацептивы с помощью гинеколога.
Если все же заболевания избежать не удалось, важно пройти полноценное лечение. Нельзя по своему усмотрению и советам знакомых покупать лекарства. Это может затруднить дальнейшую терапию и перевести воспаление в хроническую форму. При первых признаках молочницы обратитесь к гинекологу и не забудьте сообщить, если почувствовали симптомы после секса с новым партнером.
Молочница или вагинальный кандидоз – одно из самых распространенных заболеваний среди женщин, но многие из них стесняются спрашивать о ней даже у гинеколога. Обильные белые творожистые выделения, болезненность во время мочеиспускания, зуд и жжение в паху, неприятные ощущения во время секса – все это признаки молочницы.
Всем известно, что молочница – заразное заболевание. Ее возбудитель – грибок Кандида, который передается от человека к человеку различными путями, в том числе и половым. Поэтому чтобы кандидозом не заболел мужчина, во время сексуального контакта с партнершей больной молочницей, рекомендуют использовать презерватив. И тут возникает резонный вопрос: “А может ли мужчина заразить женщину молочницей?”.
Миллионы ревнивых жен, измученные регулярно появляющимися симптомами молочницы, хотели бы получить конкретный ответ на этот вопрос и наконец-то поставить точку отношениям с мужчиной, которого они подозревают в заражении. Однако даже самые известные ученые всего мира до сих пор не могут прийти к однозначному ответу на этот вопрос и твердо заявить: “Да, молочница к женщине возвращается снова и снова потому, что ей изменяет партнер”.
Если женщина задаст этот волнующий ее вопрос своему гинекологу, то, скорее всего, его ответ будет таким: “Молочница не является венерическим заболеванием. Она любит возвращаться, как бумеранг, только тем женщинам, у которых слабый иммунитет или имеются нарушения кислотно-щелочного баланса влагалища”.
Передача грибков Кандида от мужчины к женщине осуществляется не всегда. Нельзя с полной уверенностью утверждать, что мужчина обязательно заражен, если он занимался сексом с инфицированной женщиной. Патогенные микроорганизмы попадают на половые органы при контакте, однако они не размножаются у здоровых мужчин с сильным иммунитетом, соблюдающих гигиену половых органов.
А вот у женщин значительно выше риск инфицирования, так как женские половые органы имеют складки, где созданы оптимальная влажность и тепло, способствующие быстрому размножению патогенных микроорганизмов. Согласно статистике, в 4-х из 10-ти случаев передача молочницы происходит половым путем. Это значит, в остальных 6-ти случаях причиной возникновения кандидоза является не секс с инфицированным мужчиной, а общее ослабление организма из-за перенесенных заболеваний, стрессов, диеты, недосыпаний, гормональных изменений в организме и нарушения обмена веществ.
Гинекологи уверены, что возвращается молочница вновь и вновь обычно тем женщинам, которые психически настроены на болезнь. Ведь женщина, которая постоянно подозревает мужа и требует у него объяснения, почему зуд и жжение во влагалище проходят после лечения, а при половом контакте с ним возобновляются опять с новой силой, всегда находится в нервном напряжении.
На самом деле, объяснить причину регулярных рецидивов молочницы просто. Часто у мужчин нет выраженных клинических симптомов молочницы, но при этом они являются носителями заболевания. Поэтому лечиться от молочницы надо вдвоем, а не только женщине. Ей надо применять лекарства в виде свечей, а ему подойдёт крем, или оба партнёра могут использовать таблетки.
Многие современные противогрибковые средства помогают избавиться от неприятных симптомов молочницы уже на второй день с начала лечения, но это не значит, что дальше можно не применять свечи, крема, гели и таблетки. Если не закончить лечение, молочница может вернуться. Полное лечение молочницы занимает около 7 дней, в запущенных случаях – две недели. Чем быстрее начата терапия, тем легче избавиться от молочницы. Откладывать лечение нельзя: запущенная инфекция нередко приводит к уретриту, циститу или цервициту.
В клинической практике врача заражение кандидозом от полового партнера не считается главным фактором. Дрожжеподобные грибы Кандида являются представителями нормальной микрофлоры и встречаются они даже у совершенно здоровых людей. Как правило, их много в кишечнике. Именно из него они расселяются по всему организму.
Но кандидоз не развивается беспричинно. Если молочница часто возвращается, то это серьезный повод задуматься о своем здоровье. Может, у вас есть скрытое хроническое заболевание или ваш уровень жизни далёк от здоровой. Попробуйте, избавиться от лишних килограммов, откажитесь от вредных привычек, начните правильно питаться и больше двигайтесь. Занявшись улучшением качества своей жизни, можно повысить иммунитет и навсегда избавиться от молочницы.
Обратите внимание, если молочница повторно появляется сразу после менструации, то причиной этого может быть пользование тампонами. Женщинам, часто болеющим молочницей, лучше во время менструации использовать прокладки, а не тампоны. Прокладки следует менять через каждые 4 часа и не забывать при этом каждый раз подмываться, используя специальные средства для интимной гигиены.
Почему появляется молочница при смене партнера?
Молочница после смены сексуального партнера – это одна из причин появления этого заболевания. Эта коварная болезнь приносит неприятные ощущения, зуд и жжение в области половых органов. В медицине ее называют кандидоз.
Почему появляется молочница?
Смена партнера приводит к изменениям микрофлоры влагалища. Нарушение баланса микрофлоры, вызывает размножение дрожжевых грибов рода Кандида. Эти грибки присутствуют в организме каждой женщины. Как только нарушается микрофлора, грибки начинают размножаться. Тогда врач ставит диагноз – молочница.

Дрожжеподобные грибки из рода Кандида относятся к нормальной условно-патогенной флоре и не вызывают дискомфорта, но при совокупности определенных факторов (длительная терапия антибиотиками или кортикоидами, эндокринопатии, иммунодефициты, гормональный дисбаланс) происходит активация их роста и размножения, как итог – острая форма кандидоза. Многих женщин (да и мужчин) беспокоит такой вопрос – передается ли молочница партнеру посредством полового акта?
Как передается кандидоз?
На самом деле, существует несколько основных путей передачи Кандиды Альбиканс.
Рассмотрим то, как передается кандидоз:
- Через бытовые предметы.
- Возможно самозаражение.
- Инфицирование в период новорожденности.
- Половой путь.
Любые грибки, в том числе и Кандида, размножаются с помощью спор, которые способны выживать в окружающей среде длительное время.
Таким образом, при попадании спор дрожжеподобных грибков на постельное белье, вещи личной гигиены, предметы быта, последние становятся источником инфекции. Полость рта богата на микроорганизмы, в число которых могут входить и Кандиды, поэтому каждому члену семьи желательно иметь отдельный набор посуды, особенно, если у кого-то установлено кандидозоносительство.
Вдобавок к этому заражение возможно при использовании общественных душевых кабинок в бассейнах, спортивных залах, где найти грибки можно на кранах, поручнях, поддонах. С особой осторожностью следует относиться к посещению общественных бань и саун. При недостаточной или отсутствии дезинфекции помещений в них могут оставаться грибковые споры, которые, попадая в организм, становятся причиной болезни.
Молочница передается и путем самозаражения. Грибки локализуются не только в урогенитальном тракте, ротовой полости и на кожных покровах, но также их большое количество находится в органах ЖКТ.
Несоблюдение интимной гигиены (редкое принятие душа или ванны, неправильная техника подмывания – от анального сфинктера к половым органам), ношение синтетического белья могут спровоцировать попадание возбудителей из перианальной области на слизистые оболочки вульвы и влагалища.
Женский организм устроен таким образом, что распространение инфекции происходит быстро и легко, так как расстояние между промежностью и анальным отверстием не велико, а мочеиспускательный канал имеет маленькую длину.
Также передается кандидоз через инфицированные родовые пути матери. Вероятность заражения молочницей во внутриутробном периоде мала, но не исключена. Мицелии грибков часто обнаруживают в оболочках пуповины, дольках плаценты и в околоплодных водах. В приведенном случае ребенок уже рождается с клиническими проявлениями кандидоза кожи и полости рта.
Вероятнее всего передача ребенку инфекцию во время родов. Если у женщины зарегистрирована острая стадия молочницы, то шанс заражения составляет около 65-70 %. Именно поэтому, на момент беременности рекомендуется пройти курс терапии разрешенными лекарственными средствами.
В первые 12 месяцев жизни ребенка заражение происходит через слюнную жидкость и грудное материнское молоко. Ввиду незрелости иммунитета и высокой восприимчивости организма болезнь распространяется быстро и вызывает соответствующую клинику. Отсутствие должной и своевременной терапии приведет к персистенции грибков и в будущем ребенок станет носителем.
Отвечая на вопрос, передается ли кандидоз половым путем, стоит отметить, что согласно медицинским исследованиям это не главный механизм передачи инфекции. На самом деле вульвовагинальный кандидоз всего лишь в 30 % случаев связан с половой передачей болезни.
И только у 5-15% половых партнеров пациенток с молочницей выявляют кандидозоносительство, но при этом концентрация возбудителя на коже головки полового члена, в основном, низкая или недостаточная для инфицирования полости влагалища.
Однако после орально-генитальных контактов риск инфицирования значительно возрастает. Особенно это касается людей, которые являются носителями Кандид в полости рта (слизистая языка, щек, губ и слюна содержат грибки в большей концентрации, чем, к примеру, крайняя плоть пениса). Поэтому элиминация возбудителя из ротовой полости и слизистой пениса полового партнера способствует меньшей частоте развития рецидивов.
Профилактика передачи грибка от женщины к мужчине
Соблюдение ряда рекомендаций позволит минимизировать риски передачи инфекции половому партнеру.
Вот наиболее актуальные из них:
- Оба партнера должны регулярно проходить комплексное обследование, включающее диагностирование патогенного титра грибков.
- На момент лечения острой формы молочницы полностью исключаются половые контакты до полной элиминации грибков из полости влагалища.
- Возможно нанесение местных антимикотических кремов, мазей или гелей на кожу головки и крайней плоти полового члена для их защиты от инфекции (курс, как правило, составляет 10-14 дней).
- При хронических формах болезни женщина должна регулярно проводить противорецидивное лечение молочницы.
- Предметы интимной гигиены (мочалка, зубная щетка, полотенца и т.д.) должны быть отдельными для каждого партнера.
- Регулярная санация ротовой полости (антисептические и противогрибковые растворы) также позволит предупредить заражение молочницей.
- Не стоит забывать и о барьерных средствах контрацепции (презервативы).
В заключение нужно отметить, что хоть и в 30% случаев, но кандидоз передается половым путем, однако эта болезнь не причисляется к венерическим. Если женщина будет следовать всем рекомендациям по лечению и профилактике молочницы, то вероятность заражения партнера сведется к нулю.
Для того чтобы узнать, как заразиться молочницей, необходимо понимать, что это за болезнь и к чему она приведет. Взрослые женщины хорошо знакомы с такой проблемой как молочница, они понимают, что это заболевание — одно из неприятных периодов в жизни женщины.
Вылечить молочницу не просто, чтобы победить кандидоз нужно понять, как заразиться ею, передается ли молочница половым путем, можно ли заразиться молочницей от мужчины.
Процесс заражения молочницей
Развитию заболевания способствует, живущий в теле человека микроорганизм, под названием Candida (Кандида), поэтому научное название болезни — кандидоз.
Этот вид дрожжевого грибка может сосуществовать в человеческом организме на протяжении долгих лет. Все дело в том, что его количество не превышает норму, а поэтому болезненные симптомы молочницы не проявляются.
Как только нормальные условия существования этого микроорганизма будут нарушены, он начнет активно распространяться в своей среде обитания, вызывая болезненное проявление.
Причины заражения молочницей бывают: внутренние и внешние.
Дело в том, что организм может спровоцировать болезнь внутри себя. Для этого необходимы условия: ослабленная иммунная система, благоприятные условия для размножения грибковых бактерий.
Как проявляется молочница?
Люди заблуждаются, думая, что молочница проявляется только в области половых органов. Отличная среда для развития кандидоза – это слизистая, поэтому грибковая бактерия может размножаться во рту. Актуальным местом проявления молочницы остаются половые органы у женщин. У женской половины населения бактерия кандида развивается быстрее, чаще из-за особенностей половых и детородных органов.
У всех женщин молочница проявляется одинаково. Основные симптомы – это выделения из влагалища. Во всех случаях они густые (творожистые), имеют неприятный рыбный запах и жёлтый цвет. Больные отмечают колющие боли во время мочеиспускания.
Передается ли молочница мужчинам?
Как мы говорили, эта бактерия есть у каждого в организме, заболеть может любой человек. Мужчины страдают от молочницы реже женщин.
Дело в том, что женское влагалище более приспособлено для появления и развития кандидоза, по сравнению с мужскими половыми органами, да и кандидоз у мужчин лечится быстрее.
Какие симптомы молочницы у мужчин?
К основным симптомам грибка у мужчин относятся:
- появление зуда;
- режущие боли во время мочеиспускания;
- болевые ощущения после секса;
- творожный белый налёт на головке члена;
- появляются покраснения и небольшие язвы на крайней плоти;
- сухая слизистая оболочка.
Как передается кандидоз?
Молочница относится к заболеваниям интимного характера. Ее проявления могут доставить носителю массу проблем, которые касаются физического и психологического состояния человека.
Каждая женщина, которая заболела молочницей, переживает на счет партнера, так как молочница передается половым путем.
Другой вопрос, который беспокоит женщин, касается того может ли мужчина заразить женщину молочницей, как этого избежать.
Возможность бытового заражения молочницей
Врачи отмечают, что Candida – это очень живучий вид грибка. Даже если бактерия покидает среду обитания, она может продолжать своё существование и активно передаваться. Именно поэтому пути заражения молочницы могут оказаться непредсказуемыми. Грибком можно заразиться от таких предметов, как: мыло, мочалки, средства личной женской гигиены и, даже, постельное бельё. Нередки случаи, когда молочница передается через воду (в бассейне или ванной). Для того чтобы не заразиться молочницей, необходимо соблюдать гигиену.
Связь между сексом и молочницей
В первую очередь необходимо понимать, что молочница заразна. И передача этого заболевания, посредством занятия сексом, является самым распространённым. Так как во время полового акта, слизистые партнёров, имеют непосредственный контакт, то передача бактерий грибка происходит незамедлительно. Необходимо понимать, что опасность в заражении молочницей, скрывается не только в вагинальном сексе. Бактерия может развиваться во всех местах, где есть слизистая и поэтому опасность заражения представляет и оральный и анальный секс.
Врачи заявляют, что если болезненное проявление грибка кандиды диагностировано у одного из партнёров, то лечить его нужно двоим. Врачи рекомендуют прекратить половые акты во время лечения молочницы.
Во многих случаях молочница не проявляет никаких симптомов у мужчин, тем не менее, они не становятся незаразными от этого. Исходя из этого, болезнь легко передается женщине, поэтому важно проходить полный курс лечения вдвоем.
Как избавится от молочницы?
Бактерия Кандида находится у каждого человека, но не является болезненной до того момента, пока ее количество не превысит норму. Как при любом заболевании, необходимо исключать причины появления заболевания. Чтобы не заразиться молочницей нужно соблюдать простые правила:
- Постоянно поддерживать здоровую микрофлору организма.
- Иметь постоянного и проверенного партнёра.
- Соблюдать личную гигиену.
- Соблюдать нормальную половую жизнь.
Врачи утверждают, что самостоятельное лечение не всегда эффективно.
При использовании народных методов или лекарственных препаратов из рекламы, вы сможете избавиться от проявления симптомов. Причина останется, будет проявляться вновь.
Чтобы избавиться от молочницы потребуется обследование, которое подскажет, с чего необходимо начать, так как необходима полная очистка организма от грибка кандиды.
Лечение кандидоза — долгий, сложный процесс, который требует комплексного лечения, поэтому лучше доверить свое здоровье и здоровье партнера в руки специалисту.